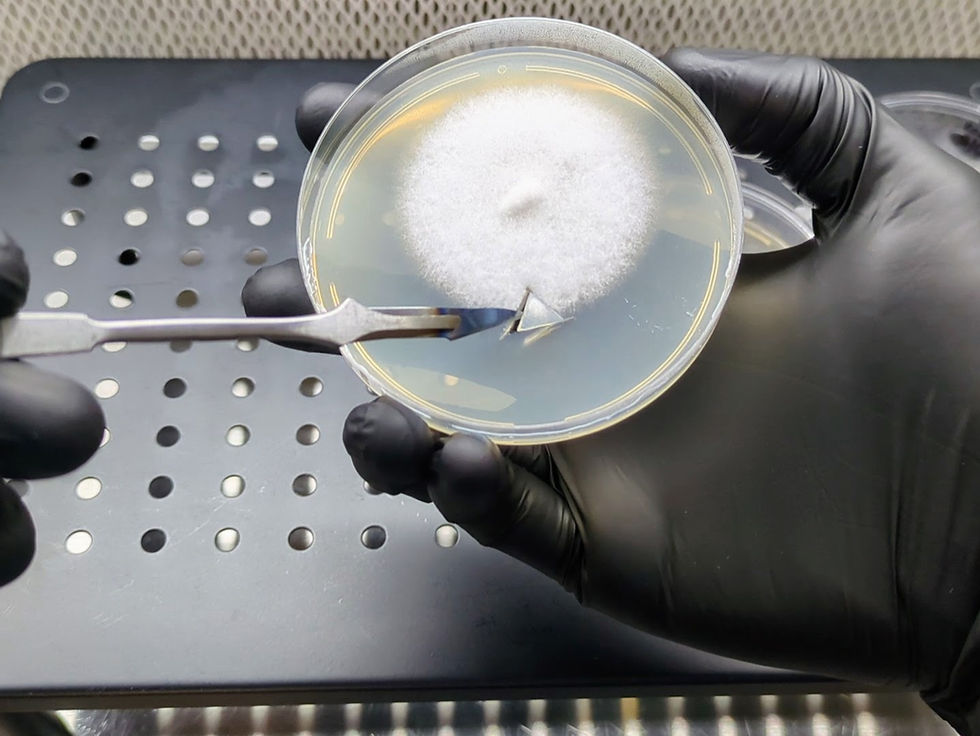
How to Perform an Agar Transfer

How to Inoculate Substrate: A Step-by-Step Guide
- Harold Evans

- Feb 9
- 3 min read
Updated: Oct 15
Inoculating substrate is a critical step in mushroom cultivation, setting the foundation for strong, healthy mycelial growth. By properly introducing grain spawn to a prepared substrate, you create an environment where mycelium can thrive and expand, ultimately leading to robust fruiting. Whether working with nutrient-rich supplemented substrates or coir-based bulk substrates, following the correct process ensures consistent success.

Understanding Substrate Inoculation
The substrate acts as the primary growing medium for mushrooms, providing essential nutrients and moisture for mycelial expansion. The choice of substrate depends on the mushroom species being cultivated and the grower's setup.
Supplemented Substrates (sterilized): Typically made from hardwood sawdust, wood chips, and nutrient additives such as bran or soybean hulls. These require careful handling to avoid contamination.
Coir-Based Substrates (pasteurized): Consist of coco coir and vermiculite, often used for species that thrive in non-sterile environments.
Regardless of the type, proper inoculation ensures even mycelial distribution, faster colonization, and a higher chance of success.
What You’ll Need
Before beginning, gather these essential materials:
Fully Colonized Grain Spawn: The inoculant, rich with mushroom mycelium.
Substrate: Choose between:
Supplemented Substrate: Sterilized sawdust-based mixtures with added nutrients.
Coir-Based Substrate: A pasteurized blend of coco coir and vermiculite.
Sterile Environment:
For Supplemented Substrates: Use a still air box (SAB) or laminar flow hood to maintain sterility.
For Coir-Based Substrates: A clean workspace and gloves are sufficient.
Gloves: To minimize contamination risks, especially when handling coir-based substrates.
Step 1: Inoculating the Substrate
The inoculation process differs based on the type of substrate being used.
For Supplemented Substrates (Sterilized):
Ensure a Sterile Environment: Work inside a SAB or under a laminar flow hood to prevent airborne contamination.
Open the Sterilized Substrate Bag: Minimize exposure by carefully opening the bag inside the sterile workspace.
Add Grain Spawn: Introduce 10–20% grain spawn by weight (e.g., 3–6 ounces per 2.2 pounds/1 kg of substrate).
Mix Thoroughly: Seal the bag and gently knead the contents to distribute the spawn evenly. Avoid over compaction, as airflow is crucial for colonization.
For Coir-Based Substrates (Pasteurized):
Wear Clean Gloves: This helps minimize contaminants from hands.
Measure and Add Grain Spawn: Use a spawn-to-substrate ratio of 1:2 to 1:4 by volume:
1 quart of grain spawn per 2 quarts of substrate (1:2 ratio).
1 quart of grain spawn per 4 quarts of substrate (1:4 ratio).
Thoroughly Mix: Ensure an even distribution of spawn throughout the substrate for consistent colonization.
Level the Surface: Gently pack the mixture into the container or monotub, keeping it level to prevent side pinning.
Optional: Add a thin, ¼-inch top layer of coir to protect exposed grain and promote even surface colonization.
Step 2: Sealing and Storing the Inoculated Substrate
Once the substrate is inoculated, it must be properly sealed and stored to promote colonization.
Sealing: Ensure containers or bags are closed securely while allowing gas exchange. Keep the lid on your container or fold and clip the bag.
Storage Conditions: Keep the substrate in a well-ventilated area at 70–80°F (21–27°C).
Light Exposure: Indirect light is preferable—complete darkness is not required for colonization.
Minimal Disturbance: Avoid frequent handling, as this can disrupt colonization progress.
Step 3: Monitoring Colonization
Over the next 2–4 weeks, check for signs of colonization:
White Mycelium Growth: Healthy mycelium will appear as fluffy, white strands expanding evenly through the substrate.
Moisture Levels: The substrate should remain slightly moist but not overly wet.
Contamination Signs: Unusual colors such as green, black, or orange indicate contamination. Discard affected batches immediately to prevent spread.
Step 4: Transitioning to Fruiting Conditions
Once the substrate is fully colonized, it’s time to prepare for fruiting.
Confirm Full Colonization: The substrate should be completely white with no uncolonized patches.
Introduce Fruiting Conditions: Adjust temperature, humidity, and airflow to trigger mushroom formation.
Monitor for Pinning: Tiny mushroom primordia (pins) should begin forming within days of introducing fruiting conditions.
Tips for a Successful Inoculation Process
Maintain Sterility: Always work in the cleanest environment possible, especially with sterilized substrates.
Ensure Even Mixing: Unevenly distributed spawn can lead to patchy colonization and slow growth.
Monitor for Contamination: Any unusual odors or colors suggest contamination—healthy mycelium should have a light, earthy mushroom scent.
Avoid Overpacking the Substrate: Compaction reduces airflow, which can stall colonization.
By following these steps, you’ll create an ideal environment for mycelium expansion, setting the stage for a successful mushroom grow.
Final Thoughts
Inoculating substrate is a crucial part of the mushroom cultivation process. Proper preparation, mixing, and storage ensure strong mycelial growth, reducing the risk of contamination and speeding up colonization. Whether using a supplemented or coir-based substrate, careful attention to technique will lead to healthier yields and more consistent harvests.

Comments